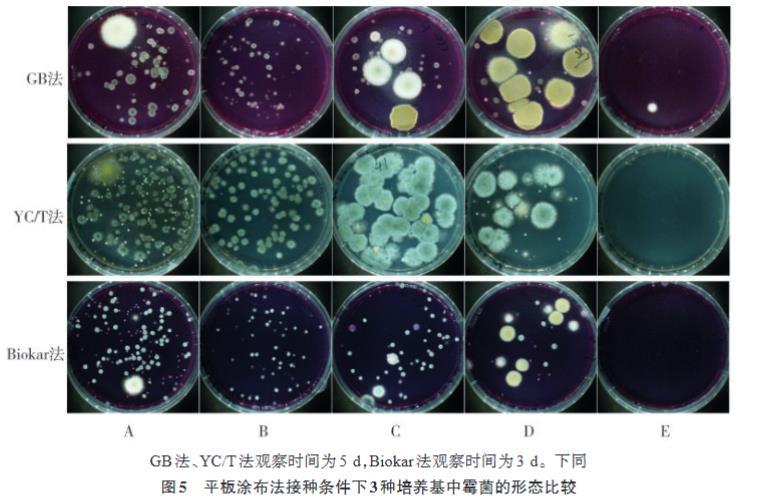
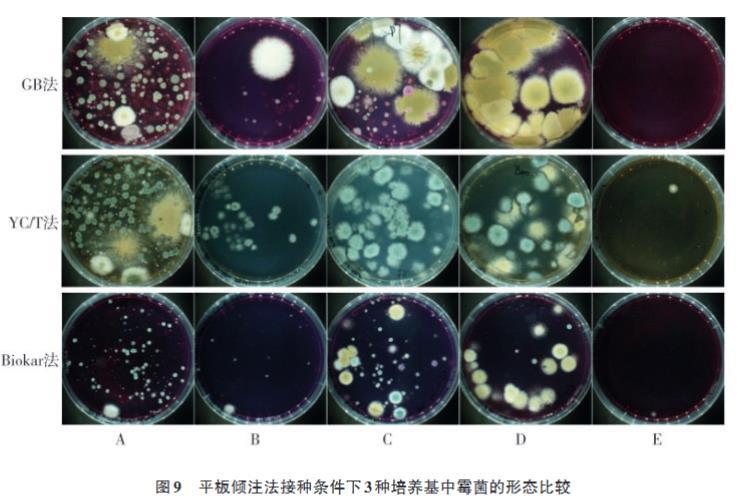

雪茄烟中霉菌培养基种类筛选、计数方法适用性研究(二)
1.3试验方法
1.3.1样品稀释
每个样品各称取25 g,用无菌剪刀剪碎,置于无菌均质袋中,加入225 mL无菌磷酸盐缓冲液,均质器3挡均质3 min,取均质后样液梯度稀释,按照前期对样品中霉菌含量的评估,依次制备4个稀释梯度(10⁻¹,10⁻²,10⁻³,10⁻⁴)。每个样品3次重复,进行稀释接种。
1.3.2接种和培养
分别使用平板倾注法和平板涂布法在3种培养基上进行平行试验,最后对3种培养基及两种接种方式进行比较。
平板倾注法(QZ):先吸取1 mL各样品的梯度稀释液于培养皿中,再将20~25 mL 45℃左右的高压蒸汽灭菌后的培养基倾倒于培养皿中。然后沿同一时针方向轻微旋转培养皿使样品与培养基混合均匀,待培养基完全凝固后用封口膜密封,标记后置于恒温恒湿培养箱内于28℃±1℃正置培养。其中GB法与YC/T法需培养至第5天,Biokar法需培养至第3天。
平板涂布法(TB):吸取各样品的梯度稀释液于各培养基表面(每个稀释度分别吸取0.333 mL接种量并分别加入到3块已提前制备好的培养基平板中),后用一次性无菌L型涂布棒涂抹均匀,待培养基表面水分晾干后密封进行正置培养,培养及计数方法与平板倾注法相同。具体技术路线及方法简称如图1所示。

图1技术路线
1.3.3霉菌判读,计数及数据统计
按照各培养基特点直接肉眼观察(必要时使用放大镜)判别霉菌形态。
平板倾注法(最低检出限10 CFU/g)霉菌计数公式:
霉菌含量=(∑ᵢ₌₁Qᵢ/3)×T(1)
式中:Qᵢ为每个重复的霉菌菌落总数;i为重复次数;T为稀释倍数。
平板涂布法(最低检出限10 CFU/g)霉菌计数公式:
霉菌含量=(∑ᵢ₌₁Tᵢ/3)×T(2)
式中:Tᵢ为每个重复的霉菌菌落总数;i为重复次数;T为稀释倍数。
按照GB 4789.15—2016进行霉菌菌落计数。
1.4数据分析
使用Microsoft Excel 2010软件进行数据整理,将所检测霉菌计数结果转化为以10为底数的对数值(未检出样品的对数值按0.7统计),采用SPSS 26.0软件进行独立样本T检验,评价各方法对霉菌计数结果的差异显著性。
使用Med Calc®Version 19.0.4软件绘制Bland-Altman图,其基本原理是计算出两方法测量结果的一致性界限,并以图形方式直观反映,同时根据实际测量结果判断两种方法是否具有一致性。
2结果与讨论
2.1霉菌计数方法比较
2.1.1 3种培养基平板涂布法的比较


对3种培养基平板涂布法霉菌计数结果分别进行Bland-Altman图比较,如图2,图3和图4所示。将GB法-TB,Biokar法-TB和YC/T法-TB进行比较,发现除低浓度样本中的个别数据分布在95%上下限之外,其余样本占比分别为92.31%,92.31%和89.74%的数据点落在95%上下限内,说明3种方法间检测结果一致性较好。当样品中霉菌含量低于10²CFU/g时,培养基对霉菌计数结果的影响较大,而当样品中霉菌含量高于10²CFU/g时,培养基对霉菌计数结果的一致性较好。表明3种培养基采用平板涂布法进行接种,对霉菌计数结果的影响与样品中霉菌含量有关。
如图5所示,通过对A,B,C,D,E等5个样品的菌落形态观察发现,3种培养基采用平板涂布法接种培养后样品中典型霉菌菌落形态区别较大,其中GB法与YC/T法霉菌菌落较大,形态清晰易判读。Biokar法典型菌落较小,分布均匀,更有助于计数,但较难从菌落形态上区分出不同种类的霉菌,由此推测Biokar法所用SYMPHONY Agar快速显色培养基中生长促进剂和选择性系统既可以促进霉菌的快速生长又能抑制霉菌菌丝的过度繁殖。综合比较发现,平板涂布法接种培养基上霉菌菌落全部生长于培养基表面,GB法与YC/T法的典型霉菌菌落形态最易判别,而Biokar法更易快速计数。
2.1.2 3种培养基的平板倾注法比较



对3种培养基的平板倾注法进行分析,结果如图6,图7和图8所示。从Bland-Altman图中发现,94.87%的数据点均落在95%上下限内,表明3种培养基的平板倾注法结果一致性较好。检测样品中霉菌含量低于10²CFU/g时,3种培养基在平板倾注法接种条件下与平板涂布法接种条件下表现出的霉菌计数结果一致。说明无论采用平板倾注法还是平板涂布法接种,当样品中霉菌含量低于10²CFU/g时,各培养基所对应的计数方法均存在一定的波动性。
3种培养基中平板倾注法对样品中霉菌生长状况的影响如图9所示。平板倾注法与平板涂布法相比,霉菌菌落除生长于培养基表面外,还在培养基内部呈现出不同的立体生长形态。YC/T法和GB法菌落生长形态相似,部分霉菌生长速率过快,菌落易蔓延,相互交错,影响计数。Biokar法霉菌生长速率较慢,更利于霉菌计数。
相关新闻推荐
3、毕赤酵母植酸酶发酵工艺优化:比生长速率多少时甲醇流加补料效果最为理想?
